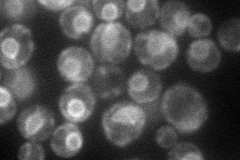
YJL196C
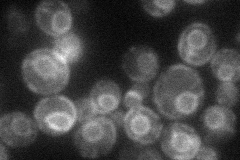
YJL196C
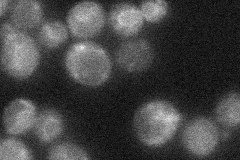
YJL196C
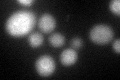
YJL196C
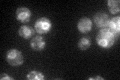
YJL196C

View description
Elongase I, medium-chain acyl elongase, catalyzes carboxy-terminal elongation of unsaturated C12-C16 fatty acyl-CoAs to C16-C18 fatty acids
Localization:
Intensity:
Fold change:
Significance:
-
C’ GFP library in SD

ER52.67 -
N' NOP1pr-GFP in SD
ER55.5378 -
N' TEF2pr-mCherry in SD
ER34.1004 -
N' NATIVEpr-GFP in SD
ER22.9707 -
N' TEF2pr-VC and Cyto-VN in SD

below threshold25.0983 -
C’ GFP library in SD+DTT
ER32.760.62Yes -
C’ GFP library in SD+H2O2

ER41.290.78No -
C’ GFP library in Starvation Media
ER66.881.26No -
C’ GFP library on the background of Pup2-DaMP

ER -
C’ GFP library on the background of CCT mutant

ER43.07640.817751No
